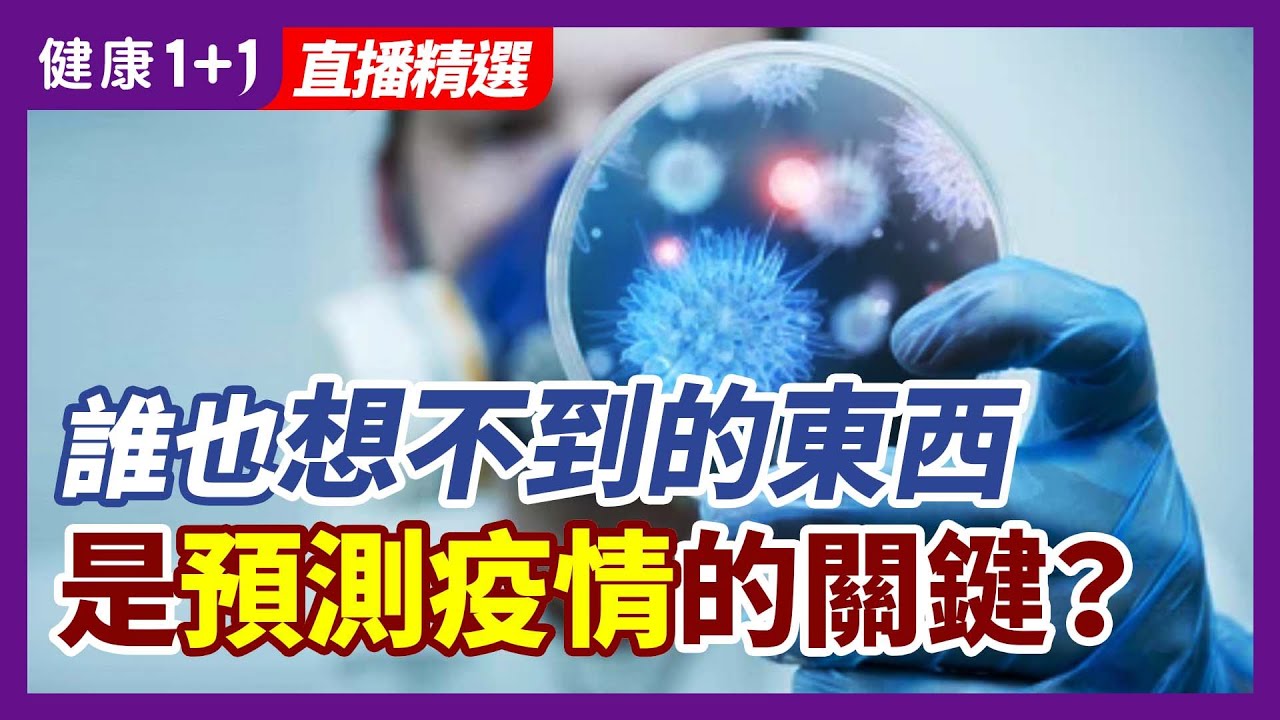

《紐約時報》一篇報導指出,CDC在兩年來的疫情中收集了很多數據,但是有大量數據沒有公開。從。CDC一直是指導疫情下民眾與醫療的關鍵指南,但是關於疫情,甚至疫苗,有些CDC沒告訴你的2件事,到底是哪兩件?
?今日專家
林曉旭 博士
美國病毒學專家、前美國陸軍研究所病毒系實驗室主任
+ 美國微生物學博士
+ 前美國陸軍研究所病毒學研究員
+ 美軍醫療服務軍官
+ 病毒系實驗室主任
+ 沃爾特 · 里德陸軍研究所病毒病科的微生物學家
+ 汎美美國領導人和導師制PPALM會員服務副總裁
請關注:Global Health Watch with Dr. Sean Lin
https://1.730795.xyz/aaabbbccc/https/www.youtube.com/channel/UCiXTq7bTUDXB-pQ0ZVzZnCg/videos
—
⭕️ 歡迎訂閱 + 按小鈴鐺 ? https://1.730795.xyz/aaabbbccc/https/www.youtube.com/channel/UC8I3-FAdFC-S9NyT204lTIw?sub_confirmation=1
⭕️ 支持我們? https://donorbox.org/health1plus1
⭕️ 會員網站? https://health1plus1.com (提供數據來源、會員特別節目、文字直播版等)
—
收聽Podcast?https://podcasts.apple.com/us/podcast/健康1-1/id1531011217
—
‣‣ 臉書 ► https://www.facebook.com/health1plus1/
‣‣ IG ► https://www.instagram.com/health1plus1/
‣‣ Pinterest ► https://www.pinterest.com/health1plus1/
‣‣ 推特 ► https://twitter.com/1_health1
‣‣ SafeChat ► https://safechat.com/channel/2788856500089034720
‣‣ 新!唐!人:官網 ► d1btjb6bfu6r53.cloudfront.net/health
‣‣ 大紀元官網 ► dajiyuan.com/health
?本節目首飾贊助:神韻shop
網址:https://www.shenyunshop.com
https://www.shenyun.com/utm_source=health1+1
聯繫我們:[email protected]
—
00:00 CDC沒告訴你的事!
08:46 2~3劑疫苗免疫低下者保護力
17:45 擔憂會讓人誤會疫苗沒效果?
—
觀看更多:
直播精選 – https://bit.ly/3fI1GeG
林曉旭|直播精選 – https://bit.ly/31aPcs2
疫情 · 病毒 – https://bit.ly/3vXWhaS
疫苗 · 新冠 – https://bit.ly/2ZA8Mhe
—
CDC未公開數據首次披露:誰也想不到的東西,是預測疫情的關鍵?| 健康1+1 · 直播
#疫情 #boost疫苗 #CDC
—
© All Rights Reserved.



![[ID: kNdd1Ncrg1M] Youtube Automatic](/wp-content/uploads/2025/10/id-kndd1ncrg1m-youtube-automatic-360x203.jpg)
![私密:[ID: I2U1Q7RN4YU] Youtube Automatic](/wp-content/uploads/2025/10/id-i2u1q7rn4yu-youtube-automatic-360x203.jpg)
![[ID: P95iI2rv0aY] Youtube Automatic](/wp-content/uploads/2025/10/id-p95ii2rv0ay-youtube-automatic-360x203.jpg)
![[ID: BABAi5TLl8c] Youtube Automatic](/wp-content/uploads/2025/10/id-babai5tll8c-youtube-automatic-360x203.jpg)
![私密:[ID: 9MejE60Ib84] Youtube Automatic](/wp-content/uploads/2025/10/id-9meje60ib84-youtube-automatic-360x203.jpg)
![私密:[ID: dmeMvIktmYU] Youtube Automatic](/wp-content/uploads/2025/10/id-dmemviktmyu-youtube-automatic-360x203.jpg)
![私密:[ID: rkBdgpONIfw] Youtube Automatic](/wp-content/uploads/2025/10/id-rkbdgponifw-youtube-automatic-360x203.jpg)
![私密:[ID: P29cmcsjMqs] Youtube Automatic](/wp-content/uploads/2025/10/id-p29cmcsjmqs-youtube-automatic-360x203.jpg)
![[ID: pl7Fhi16-rQ] Youtube Automatic](/wp-content/uploads/2025/10/id-pl7fhi16-rq-youtube-automatic-360x203.jpg)
![[ID: hvI5Gaym16I] Youtube Automatic](/wp-content/uploads/2025/10/id-hvi5gaym16i-youtube-automatic-360x203.jpg)
![[ID: BoJpcAayV5k] Youtube Automatic](/wp-content/uploads/2025/10/id-bojpcaayv5k-youtube-automatic-360x203.jpg)
![[ID: GRrsgrwjBEw] Youtube Automatic](/wp-content/uploads/2025/10/id-grrsgrwjbew-youtube-automatic-360x203.jpg)
![[ID: 1qlpDXYEneE] Youtube Automatic](/wp-content/uploads/2025/10/id-1qlpdxyenee-youtube-automatic-360x203.jpg)
![私密:[ID: ri8viExBKkA] Youtube Automatic](/wp-content/uploads/2025/10/id-ri8viexbkka-youtube-automatic-360x203.jpg)
![[ID: WP9IJFET21Q] Youtube Automatic](/wp-content/uploads/2025/10/id-wp9ijfet21q-youtube-automatic-360x203.jpg)
![[ID: 6dO7yZJO3gQ] Youtube Automatic](/wp-content/uploads/2025/10/id-6do7yzjo3gq-youtube-automatic-360x203.jpg)
![[ID: gnsB2YwHNFw] Youtube Automatic](/wp-content/uploads/2025/10/id-gnsb2ywhnfw-youtube-automatic-360x203.jpg)
![[ID: vb2dZB9VHEo] Youtube Automatic](/wp-content/uploads/2025/10/id-vb2dzb9vheo-youtube-automatic-360x203.jpg)
![[ID: GKKievt_NII] Youtube Automatic](/wp-content/uploads/2025/10/id-gkkievtnii-youtube-automatic-360x203.jpg)
![[ID: vCWhbssAc1M] Youtube Automatic](/wp-content/uploads/2025/10/id-vcwhbssac1m-youtube-automatic-360x203.jpg)
![[ID: QfdK_2LmEIA] Youtube Automatic](/wp-content/uploads/2025/10/id-qfdk2lmeia-youtube-automatic-360x203.jpg)
![私密:[ID: wldkfmOuKC4] Youtube Automatic](/wp-content/uploads/2025/10/id-wldkfmoukc4-youtube-automatic-360x203.jpg)
![[ID: N4UXtkIFUKM] Youtube Automatic](/wp-content/uploads/2025/10/id-n4uxtkifukm-youtube-automatic-360x203.jpg)
![[ID: 2PYN5PxE86I] Youtube Automatic](/wp-content/uploads/2025/10/id-2pyn5pxe86i-youtube-automatic-360x203.jpg)
![[ID: 3GdaXsRvtnQ] Youtube Automatic](/wp-content/uploads/2025/10/id-3gdaxsrvtnq-youtube-automatic-360x203.jpg)
![私密:[ID: kOaT4eHM_Xw] Youtube Automatic](/wp-content/uploads/2025/10/id-koat4ehmxw-youtube-automatic-360x203.jpg)
![私密:[ID: J3uqRtiLqW0] Youtube Automatic](/wp-content/uploads/2025/10/id-j3uqrtilqw0-youtube-automatic-360x203.jpg)
![[ID: 3G8ekw7hDC8] Youtube Automatic](/wp-content/uploads/2025/10/id-3g8ekw7hdc8-youtube-automatic-360x203.jpg)
![[ID: cK12bvB0Ls8] Youtube Automatic](/wp-content/uploads/2025/10/id-ck12bvb0ls8-youtube-automatic-360x203.jpg)
![[ID: e3OHxWcG6Og] Youtube Automatic](/wp-content/uploads/2025/10/id-e3ohxwcg6og-youtube-automatic-360x203.jpg)
![[ID: _v0v_wH4t88] Youtube Automatic](/wp-content/uploads/2025/10/id-v0vwh4t88-youtube-automatic-360x203.jpg)
![[ID: p_qtsbxRIIY] Youtube Automatic](/wp-content/uploads/2025/10/id-pqtsbxriiy-youtube-automatic-360x203.jpg)
![私密:[ID: DF8tVVTSLxM] Youtube Automatic](/wp-content/uploads/2025/10/id-df8tvvtslxm-youtube-automatic-360x203.jpg)
![私密:[ID: 0nmcywbDZSE] Youtube Automatic](/wp-content/uploads/2025/10/id-0nmcywbdzse-youtube-automatic-360x203.jpg)
![私密:[ID: upwAkXKUa8U] Youtube Automatic](/wp-content/uploads/2025/10/id-upwakxkua8u-youtube-automatic-360x203.jpg)
![[ID: 4tr2VzrVD0E] Youtube Automatic](/wp-content/uploads/2025/10/id-4tr2vzrvd0e-youtube-automatic-360x203.jpg)
![[ID: 74TUOIJjq-8] Youtube Automatic](/wp-content/uploads/2025/10/id-74tuoijjq-8-youtube-automatic-360x203.jpg)
![[ID: h2YoMgbAGko] Youtube Automatic](/wp-content/uploads/2025/10/id-h2yomgbagko-youtube-automatic-360x203.jpg)
![[ID: ljKtJrVmxPA] Youtube Automatic](/wp-content/uploads/2025/10/id-ljktjrvmxpa-youtube-automatic-360x203.jpg)
![[ID: 9BFgZej8Hu4] Youtube Automatic](/wp-content/uploads/2025/10/id-9bfgzej8hu4-youtube-automatic-360x203.jpg)
![[ID: 8zfxZZbE_hw] Youtube Automatic](/wp-content/uploads/2025/10/id-8zfxzzbehw-youtube-automatic-360x203.jpg)
![[ID: 4cEMYz5U-hE] Youtube Automatic](/wp-content/uploads/2025/10/id-4cemyz5u-he-youtube-automatic-360x203.jpg)
![[ID: _CEHIMP6DKw] Youtube Automatic](/wp-content/uploads/2025/09/id-cehimp6dkw-youtube-automatic-360x203.jpg)
![[ID: eqnTb56wSEw] Youtube Automatic](/wp-content/uploads/2025/09/id-eqntb56wsew-youtube-automatic-360x203.jpg)
![[ID: kOAaj6ydqKo] Youtube Automatic](/wp-content/uploads/2025/10/id-koaaj6ydqko-youtube-automatic-360x203.jpg)
![[ID: pfQS7J2RLxo] Youtube Automatic](/wp-content/uploads/2025/10/id-pfqs7j2rlxo-youtube-automatic-360x203.jpg)
![[ID: pNdGcHM1Fas] Youtube Automatic](/wp-content/uploads/2025/10/id-pndgchm1fas-youtube-automatic-360x203.jpg)
![[ID: Q4XG90kQSs4] Youtube Automatic](/wp-content/uploads/2025/10/id-q4xg90kqss4-youtube-automatic-360x203.jpg)
![[ID: dAcEofCKIOQ] Youtube Automatic](/wp-content/uploads/2025/08/id-daceofckioq-youtube-automatic-360x203.jpg)
![[ID: ABzsog5B8-c] Youtube Automatic](/wp-content/uploads/2025/08/id-abzsog5b8-c-youtube-automatic-360x203.jpg)


![[ID: AulMlzEtcJ8] Youtube Automatic](/wp-content/uploads/2025/07/id-aulmlzetcj8-youtube-automatic-360x203.jpg)
![[ID: 35N7KKwFZwU] Youtube Automatic](/wp-content/uploads/2025/05/id-35n7kkwfzwu-youtube-automatic-360x203.jpg)
![[ID: dodRr6wwL9w] Youtube Automatic](/wp-content/uploads/2025/04/id-dodrr6wwl9w-youtube-automatic-360x203.jpg)
![[ID: r_DJ8v4SNRM] Youtube Automatic](/wp-content/uploads/2025/04/id-rdj8v4snrm-youtube-automatic-360x203.jpg)



![[ID: c-Stk3CTGcs] Youtube Automatic](/wp-content/uploads/2025/10/id-c-stk3ctgcs-youtube-automatic-360x203.jpg)
![[ID: -sN2Et3AQuA] Youtube Automatic](/wp-content/uploads/2025/10/id-sn2et3aqua-youtube-automatic-360x203.jpg)
![[ID: 2dVD8AocGKc] Youtube Automatic](/wp-content/uploads/2025/10/id-2dvd8aocgkc-youtube-automatic-360x203.jpg)
![[ID: kzS2H2A6hF4] Youtube Automatic](/wp-content/uploads/2025/10/id-kzs2h2a6hf4-youtube-automatic-360x203.jpg)







![私密:[ID: MqeGq3v5Cnw] Youtube Automatic](/wp-content/uploads/2021/07/id-mqegq3v5cnw-youtube-automatic-360x203.jpg)
![私密:[ID: K6E7SW8awUw] Youtube Automatic](/wp-content/uploads/2021/06/id-k6e7sw8awuw-youtube-automatic-360x203.jpg)
![私密:[ID: 38-SfgFh_d0] Youtube Automatic](/wp-content/uploads/2021/06/id-38-sfgfhd0-youtube-automatic-360x203.jpg)
![私密:[ID: Ms_zDOocemI] Youtube Automatic](/wp-content/uploads/2022/05/id-mszdoocemi-youtube-automatic-360x203.jpg)
![私密:[ID: 0X0C9vVYMhk] Youtube Automatic](/wp-content/uploads/2022/05/id-0x0c9vvymhk-youtube-automatic-360x203.jpg)
![私密:[ID: utaPGfuaqaY] Youtube Automatic](/wp-content/uploads/2022/04/id-utapgfuaqay-youtube-automatic-360x203.jpg)
![私密:[ID: 7Pch9Hkjg5M] Youtube Automatic](/wp-content/uploads/2022/04/id-7pch9hkjg5m-youtube-automatic-360x203.jpg)

![[ID: aZ7miYRb5X8] Youtube Automatic](/wp-content/uploads/2021/10/id-az7miyrb5x8-youtube-automatic-360x203.jpg)
![[ID: 8PJUU_NQd3I] Youtube Automatic](/wp-content/uploads/2021/10/id-8pjuunqd3i-youtube-automatic-360x203.jpg)
![[ID: 0X4Eo_V8zEI] Youtube Automatic](/wp-content/uploads/2021/10/id-0x4eov8zei-youtube-automatic-360x203.jpg)










![[ID: lFDTClB7He4] Youtube Automatic](/wp-content/uploads/2020/06/id-lfdtclb7he4-youtube-automatic-360x203.jpg)
![[ID: RXovIXwmjN4] Youtube Automatic](/wp-content/uploads/2020/06/id-rxovixwmjn4-youtube-automatic-360x203.jpg)
![[ID: sayrC86JcoE] Youtube Automatic](/wp-content/uploads/2020/06/id-sayrc86jcoe-youtube-automatic-360x203.jpg)
![[ID: 5GEMz_pvh50] Youtube Automatic](/wp-content/uploads/2021/11/id-5gemzpvh50-youtube-automatic-360x203.jpg)
![[ID: fpfbU82n-Kw] Youtube Automatic](/wp-content/uploads/2021/11/id-fpfbu82n-kw-youtube-automatic-360x203.jpg)
![[ID: 5ziZaS9yTIM] Youtube Automatic](/wp-content/uploads/2021/11/id-5zizas9ytim-youtube-automatic-360x203.jpg)
![[ID: v1CCdVFazB8] Youtube Automatic](/wp-content/uploads/2021/11/id-v1ccdvfazb8-youtube-automatic-360x203.jpg)
![私密:[ID: lDdT-5Qa7A8] Youtube Automatic](/wp-content/uploads/2025/09/id-lddt-5qa7a8-youtube-automatic-360x203.jpg)
![私密:[ID: MscVt19ghJU] Youtube Automatic](/wp-content/uploads/2025/09/id-mscvt19ghju-youtube-automatic-360x203.jpg)
![[ID: Ny-DlQGvKEw] Youtube Automatic](/wp-content/uploads/2025/01/id-ny-dlqgvkew-youtube-automatic-360x203.jpg)
![[ID: N7gZK4Du0DE] Youtube Automatic](/wp-content/uploads/2025/01/id-n7gzk4du0de-youtube-automatic-360x203.jpg)
![[ID: 1Tvrz9PEaR4] Youtube Automatic](/wp-content/uploads/2023/11/id-1tvrz9pear4-youtube-automatic-360x203.jpg)
![[ID: F5kZaR7sG7M] Youtube Automatic](/wp-content/uploads/2023/11/id-f5kzar7sg7m-youtube-automatic-360x203.jpg)
![[ID: opMKbounujc] Youtube Automatic](/wp-content/uploads/2023/11/id-opmkbounujc-youtube-automatic-360x203.jpg)
![[ID: Nu0_MU7TPqM] Youtube Automatic](/wp-content/uploads/2023/11/id-nu0mu7tpqm-youtube-automatic-360x203.jpg)




![私密:[ID: -ZjJcVArE-o] Youtube Automatic](/wp-content/uploads/2023/07/id-zjjcvare-o-youtube-automatic-360x203.jpg)
![私密:[ID: lsOzEgqYTrc] Youtube Automatic](/wp-content/uploads/2023/01/id-lsozegqytrc-youtube-automatic-360x203.jpg)
![私密:[ID: VphWFWpv_f4] Youtube Automatic](/wp-content/uploads/2022/02/id-vphwfwpvf4-youtube-automatic-360x203.jpg)
![私密:[ID: Bsyj5Xo32PI] Youtube Automatic](/wp-content/uploads/2021/11/id-bsyj5xo32pi-youtube-automatic-360x203.jpg)










![[ID: tpPk3PI77kE] Youtube Automatic](/wp-content/uploads/2025/07/id-tppk3pi77ke-youtube-automatic-360x203.jpg)
![[ID: rIObW65VxG4] Youtube Automatic](/wp-content/uploads/2025/06/id-riobw65vxg4-youtube-automatic-1-360x203.jpg)
![[ID: VJaMkcisJBM] Youtube Automatic](/wp-content/uploads/2025/05/id-vjamkcisjbm-youtube-automatic-1-360x203.jpg)
![[ID: -0le_bv2wV4] Youtube Automatic](/wp-content/uploads/2025/04/id-0lebv2wv4-youtube-automatic-360x203.jpg)
![[ID: 4mVu6i7b7zY] Youtube Automatic](/wp-content/uploads/2023/11/id-4mvu6i7b7zy-youtube-automatic-360x203.jpg)
![私密:[ID: 0uCNZ9UJMRc] Youtube Automatic](/wp-content/uploads/2023/10/id-0ucnz9ujmrc-youtube-automatic-360x203.jpg)
![私密:[ID: RgIPGGjKcZU] Youtube Automatic](/wp-content/uploads/2023/09/id-rgipggjkczu-youtube-automatic-360x203.jpg)
![[ID: Lyu4tDv3Fx8] Youtube Automatic](/wp-content/uploads/2023/09/id-lyu4tdv3fx8-youtube-automatic-360x203.jpg)
![[ID: RIxVtE7o4r0] Youtube Automatic](/wp-content/uploads/2025/10/id-rixvte7o4r0-youtube-automatic-360x203.jpg)
![[ID: EzAj5h5l3oA] Youtube Automatic](/wp-content/uploads/2025/10/id-ezaj5h5l3oa-youtube-automatic-360x203.jpg)
![[ID: hKQtjY2koyk] Youtube Automatic](/wp-content/uploads/2025/10/id-hkqtjy2koyk-youtube-automatic-360x203.jpg)
![[ID: 4DKnj2O8duU] Youtube Automatic](/wp-content/uploads/2025/10/id-4dknj2o8duu-youtube-automatic-360x203.jpg)
![[ID: YLu5wHn7D7M] Youtube Automatic](/wp-content/uploads/2025/10/id-ylu5whn7d7m-youtube-automatic-360x203.jpg)
![[ID: pNYOf91_O4o] Youtube Automatic](/wp-content/uploads/2025/09/id-pnyof91o4o-youtube-automatic-360x203.jpg)
![[ID: zqfneUH3Xzs] Youtube Automatic](/wp-content/uploads/2025/08/id-zqfneuh3xzs-youtube-automatic-360x203.jpg)
![[ID: rlmIAvc25EQ] Youtube Automatic](/wp-content/uploads/2025/08/id-rlmiavc25eq-youtube-automatic-360x203.jpg)
![[ID: dtc9qJFPktU] Youtube Automatic](/wp-content/uploads/2025/10/id-dtc9qjfpktu-youtube-automatic-360x203.jpg)
![[ID: Qzc9OJ37Llw] Youtube Automatic](/wp-content/uploads/2025/10/id-qzc9oj37llw-youtube-automatic-360x203.jpg)
![[ID: IjsVbm-qgtU] Youtube Automatic](/wp-content/uploads/2025/10/id-ijsvbm-qgtu-youtube-automatic-360x203.jpg)
![[ID: Nri2Xu0T_xk] Youtube Automatic](/wp-content/uploads/2025/10/id-nri2xu0txk-youtube-automatic-360x203.jpg)
![[ID: 0P0G0ijz3Ro] Youtube Automatic](/wp-content/uploads/2025/10/id-0p0g0ijz3ro-youtube-automatic-360x203.jpg)
![[ID: dnvBH3Jb_Fc] Youtube Automatic](/wp-content/uploads/2025/09/id-dnvbh3jbfc-youtube-automatic-360x203.jpg)
![[ID: 4vaU8f3Z014] Youtube Automatic](/wp-content/uploads/2025/09/id-4vau8f3z014-youtube-automatic-360x203.jpg)
![[ID: 4SsTlLHaUQY] Youtube Automatic](/wp-content/uploads/2025/06/id-4sstllhauqy-youtube-automatic-360x203.jpg)
![[ID: BpAL60pbUqY] Youtube Automatic](/wp-content/uploads/2025/10/id-bpal60pbuqy-youtube-automatic-360x203.jpg)
![[ID: 1Tz80kmNzq4] Youtube Automatic](/wp-content/uploads/2025/10/id-1tz80kmnzq4-youtube-automatic-360x203.jpg)
![[ID: 2v0aeyXe498] Youtube Automatic](/wp-content/uploads/2025/10/id-2v0aeyxe498-youtube-automatic-360x203.jpg)
![[ID: eLROtv1jzfE] Youtube Automatic](/wp-content/uploads/2025/09/id-elrotv1jzfe-youtube-automatic-360x203.jpg)
![[ID: 065ad_oB17U] Youtube Automatic](/wp-content/uploads/2025/10/id-065adob17u-youtube-automatic-360x203.jpg)
![[ID: Wa8CTABQzRc] Youtube Automatic](/wp-content/uploads/2025/10/id-wa8ctabqzrc-youtube-automatic-360x203.jpg)
![[ID: uw-hl4W5XqE] Youtube Automatic](/wp-content/uploads/2025/10/id-uw-hl4w5xqe-youtube-automatic-360x203.jpg)
![[ID: iovd9SLvu5c] Youtube Automatic](/wp-content/uploads/2025/10/id-iovd9slvu5c-youtube-automatic-360x203.jpg)
![[ID: 4mVu6i7b7zY] Youtube Automatic](/wp-content/uploads/2023/11/id-4mvu6i7b7zy-youtube-automatic-236x133.jpg)
![私密:[ID: 0uCNZ9UJMRc] Youtube Automatic](/wp-content/uploads/2023/10/id-0ucnz9ujmrc-youtube-automatic-236x133.jpg)
![私密:[ID: RgIPGGjKcZU] Youtube Automatic](/wp-content/uploads/2023/09/id-rgipggjkczu-youtube-automatic.jpg)
![[ID: Lyu4tDv3Fx8] Youtube Automatic](/wp-content/uploads/2023/09/id-lyu4tdv3fx8-youtube-automatic.jpg)
![[ID: DcUm4BsJwC4] Youtube Automatic](/wp-content/uploads/2023/09/id-dcum4bsjwc4-youtube-automatic.jpg)
![[ID: UBQDEciodt0] Youtube Automatic](/wp-content/uploads/2023/08/id-ubqdeciodt0-youtube-automatic.jpg)
![[ID: wbu6mmOgZzQ] Youtube Automatic](/wp-content/uploads/2023/07/id-wbu6mmogzzq-youtube-automatic.jpg)
![[ID: KDdZB3RM_lI] Youtube Automatic](/wp-content/uploads/2023/07/id-kddzb3rmli-youtube-automatic.jpg)
![私密:[ID: FDcyB0tyLAE] Youtube Automatic](/wp-content/uploads/2023/07/id-fdcyb0tylae-youtube-automatic.jpg)
![私密:[ID: K17MGozBmPQ] Youtube Automatic](/wp-content/uploads/2023/06/id-k17mgozbmpq-youtube-automatic.jpg)
![[ID: 223srquFnCE] Youtube Automatic](/wp-content/uploads/2024/11/id-223srqufnce-youtube-automatic-100x100.jpg)
![私密:[ID: cBYhiwaNHf8] Youtube Automatic](/wp-content/uploads/2025/01/id-cbyhiwanhf8-youtube-automatic-100x100.jpg)
![[ID: -8O3DtQX47I] Youtube Automatic](/wp-content/uploads/2025/01/id-8o3dtqx47i-youtube-automatic-100x100.jpg)
![[ID: WrRYBJUikPs] Youtube Automatic](/wp-content/uploads/2025/01/id-wrrybjuikps-youtube-automatic-100x100.jpg)
![[ID: 7_CtSTZBtzU] Youtube Automatic](/wp-content/uploads/2025/01/id-7ctstzbtzu-youtube-automatic-100x100.jpg)
![[ID: XGDB2PUR6CM] Youtube Automatic](/wp-content/uploads/2025/01/id-xgdb2pur6cm-youtube-automatic-100x100.jpg)
![[ID: BBkQDUHmWmo] Youtube Automatic](/wp-content/uploads/2022/03/id-bbkqduhmwmo-youtube-automatic.jpg)
![私密:[ID: UDMCSwfoJTo] Youtube Automatic](/wp-content/uploads/2022/03/id-udmcswfojto-youtube-automatic.jpg)

